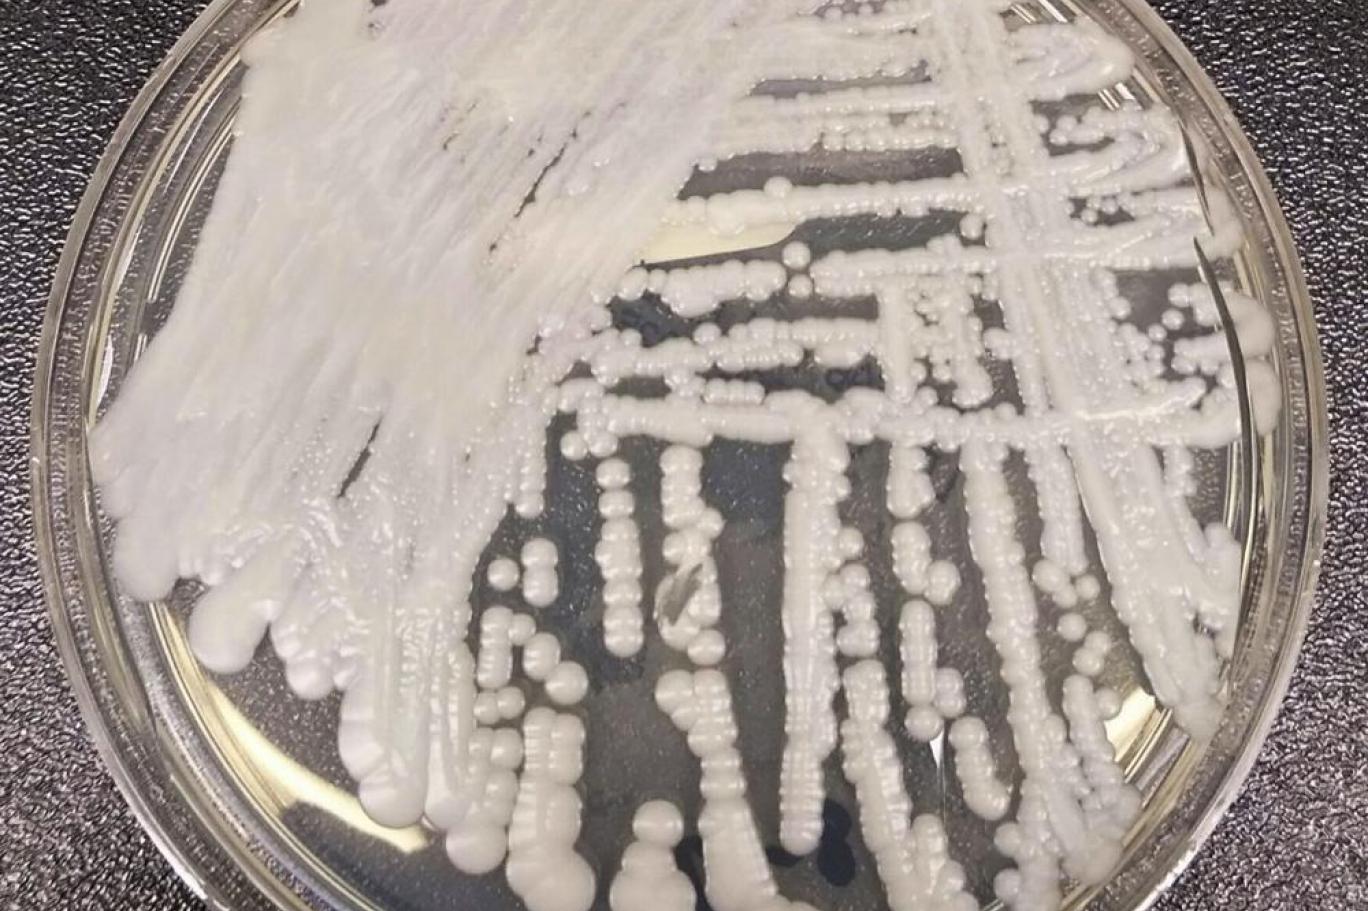

أظهرت #دراسة_جديدة احتمال مقاومة #الفطريات المسببة للأمراض لحرارة المناخ المرتفعة وتحولها إلى خطر على #صحة_البشر، في تشابه مخيف مع المسلسل التلفزيوني الناجح على شبكة (HBO) بعنوان "آخر واحد منا" الذي تجري أحداثه في أعقاب كارثة عظمى.
وكشفت الدراسة التي نشرت الأسبوع الماضي في مجلة "محاضر الأكاديمية الوطنية للعلوم" PNAS عن أن الاحتباس الحراري وأزمة المناخ قد يكونان مسؤولين عن مساعدة الفطريات في مقاومة درجات الحرارة المرتفعة وإلحاق الضرر ببني البشر.
ويكشف مسلسل "آخر واحد منا" The Last of Us، المستوحاة أحداثه من لعبة الفيديو التي تحظى بشعبية كبيرة والتي تمت الإشادة بها من قبل النقاد وتحمل الاسم ذاته، عن عالم بائس تقوم فيه فطريات الكورديسبس التي تتكيف مع الحرارة بالسيطرة على البشر وتحويلهم إلى آكلي لحوم البشر (زومبي).
اقرأ المزيد
يحتوي هذا القسم على المقلات ذات صلة, الموضوعة في (Related Nodes field)
وقالت المؤلفة المشاركة في الدراسة آسيا جوسا من كلية ديوك للطب في الولايات المتحدة: "ذلك بالضبط هو ما أتحدث عنه، باستثناء الجزء المتعلق بأكلة لحوم البشر الزومبي".
وفي حين لا يوجد تهديد مباشر من نقل البشر للعدوى الفطرية إلى بعضهم بعضاً، حذر العلماء من أن ارتفاع درجات الحرارة العالمية قد يتسبب في تغيير الميكروبات لطريقة تصرفها مع البشر أثناء الإصابة.
وتشير الدراسة إلى أنه "من المتوقع أن يؤدي ارتفاع درجات الحرارة العالمية وتغير المناخ إلى زيادة الأمراض الفطرية لدى النباتات والثدييات".
ومن المعروف أن الفطريات مثل "المبيضات" Candida و"الكربتوكوكس" Cryptococcus تصيب وتقتل الأشخاص الذين يعانون مناعة ضعيفة، لكن الغالبية العظمى من هذه الميكروبات لم تكن تستطيع النجاة مع حرارة الأجسام السليمة.
وفي الدراسة الجديدة، كشف العلماء عن أن ارتفاع درجات الحرارة أدى إلى ظهور فطر مسبب للأمراض يعرف باسم Cryptococcus deneoformans الذي يتسبب في زيادة عدد التغيرات الجينية التي قد تؤدي إلى مقاومة أعلى للحرارة، ومن المحتمل أيضاً أن تسبب أمراضاً محتملة لدى البشر.
ووجد الباحثون أنه في ظل زيادة درجات الحرارة المحيطة، يمكن أن تخضع أجزاء من جينوم الفطريات التي تسهم في تكيفها مع البيئة وأثناء العدوى لتغيرات.
وأوضحت الدكتورة جوسا: "يمكن أن يحدث ذلك بشكل أسرع لأن الإجهاد الحراري يسرع عدد الطفرات التي تحدث".
كما بيّن العلماء أنه من ضمن 800 مسبب للنمو في الوسط المختبري، كان معدل نمو بعض الطفرات أعلى بخمس مرات في الفطريات التي تم وضعها في درجة حرارة الجسم، مقارنة بتلك التي تم وضعها في بيئة عند 30 درجة مئوية.
وقالوا إن التحديات الإضافية للبقاء على قيد الحياة لدى الحيوانات ذات الاستجابات المناعية والضغوط الأخرى قد تدفع هذه الأجزاء من جينوم الفطريات إلى أن تكون أكثر نشاطاً.
وأوضح أرتورو كاساديفال، مؤلف آخر للدراسة من جامعة جونز هوبكنز في الولايات المتحدة: "هذه دراسة رائعة، تظهر كيف يمكن أن تؤثر زيادة درجة الحرارة العالمية في تطور ونمو الفطريات باتجاهات لا يمكن توقعها".
وأضاف: "فمع ارتفاع درجة حرارة العالم، يمكن أن تصبح الترانسبوزونات [عناصر الحمض النووي التي يمكن أن تغير موقعها داخل الجينوم] في فطريات التربة مثل Cryptococcus neoformans أكثر قدرة على الحركة وتزيد من التغيرات الجينية بطرق يمكن أن تعزز من قدرتها على الفتك ومقاومة الأدوية. وذلك يضيف إلى قائمة المخاوف المرتبطة بالاحترار العالمي".
ويأمل العلماء في الدراسات المقبلة أن تتم دراسة مسببات الأمراض لدى مرضى بشريين أصيبوا بعدوى فطرية منتكسة.
وقالت الدكتورة جوسا: "نحن نعلم أن هذه العدوى يمكن أن تستمر ثم تعود بتغيرات جينية محتملة. قد تسهم هذه الأنواع من التغييرات المحفزة للإجهاد في تطور السمات المسببة للأمراض في الفطريات سواء في البيئة أو أثناء العدوى. وربما تتطور بشكل أسرع مما توقعنا".
وأوضح كريغ مازن، مؤلف المسلسل المقتبس من لعبة الفيديو الناجحة، لصحيفة "هوليوود ريبورتر": "تلك حقيقة، إنها حقيقة لدرجة أن كل ما يقال عن إمكانات الفطريات وقدراتها هو صحيح. وذلك يتجلى على أرض الواقع حالياً وسوف تواصل الفطريات العمل بالأداء نفسه بلا هوادة. هناك بعض الأفلام الوثائقية الرائعة التي يمكنك مشاهدتها وهي مرعبة للغاية".
© The Independent